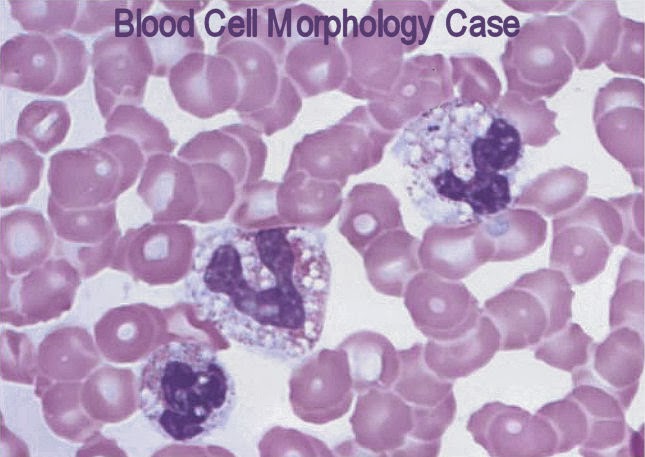
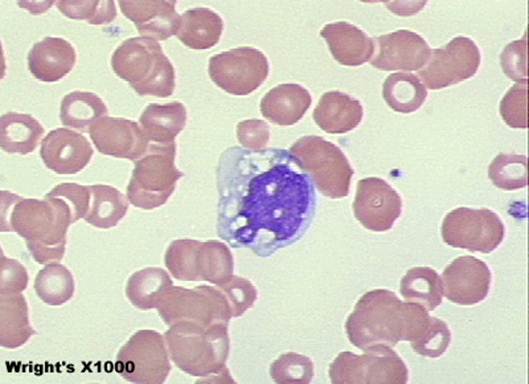

Зернистость гранулоцитов
Зернистость гранулоцитов 97 фотографий
Москва луганская улица 1
Стой ковбой слушать
Улица ломоносова петрозаводск
Улица одоевского 29
Дмрв бмв м52
Какой кошелек лучше для криптовалюты 2026
Антидепрессанты в самолете
Хорошие друзья познаются в беде
Настя садковская слепые прослушивания
Посудомоечной машине стоит вода в фильтре